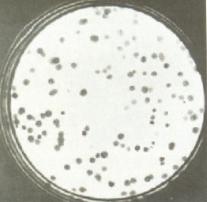
细胞美容学之父——张红凯博士

细胞美容
一种利用干细胞、端粒体以、高分子抗衰老原料及高科技美容设备针对皮肤细胞的排毒、皮肤细胞激活及皮肤细胞的修复的科学方法达到除皱、除同时让身体细胞年轻和逆龄的美容技术,被称为细胞美容,成为媒体报道和公众关注的热点,它被形容成"用细胞为细胞美容",在国外被称为是"一场美容的生物革命"。
美国国际细胞康复协会会长张红凯博士提出了细胞美容学理论雏形,同年武汉大学出版生出版他著作的《细胞美容》书籍。

研究历史
1931年,瑞士保罗尼翰医生(Dr.Paul Niehans)首次将从小羊胚胎中提取的一种鲜活细胞注射到一名甲状旁腺受损的临危病人体内,并成功挽救了其生命,后来这位病人于1962年仙逝,享年89岁,
这就是细胞活化疗法的最初起源,它的发现对人类在抗衰老领域的医学发展有着里程碑式的意义,因此Paul Niehans被世人誉称为"活细胞之父"、"羊胚胎素细胞活化治疗的创始人",罗马教皇为了表示对Dr. Paul Niehans的敬意,授封Paul Niehans为梵蒂冈科学院院士。
1931年,Clinique Paul Niehans创立,起源于Dr. PaulNiehans自己的姓名,其所创立的尼翰疗法也已广为人知,是世界上首家专业从事羊胚胎素细胞活化治疗和研发的权威机构。
2013年12月1日,美国哥伦比亚大学医学研究中心的科学家首次成功地将人体干细胞转化成了功能性的肺细胞和呼吸道细胞。
2014年4月,首个可用于人体的干细胞制造中心获得爱尔兰药品管理局的许可,在爱尔兰国立戈尔韦大学成立。
2014年10月2014年美国国际细胞康复协会会长张红凯博士提出了细胞美容学理论雏形,同年武汉大学出版生出版他著作的《细胞美容》书籍。

第一章:细胞美容学概论

一、细胞美容学:
细胞美容学是从生物胚胎学、细胞学衍生出的新型学科,是对人体组成的基本原始最小单位---细胞,进行研究、分析,通过对细胞排毒、细胞激活、细胞修复使细胞组织代谢功能恢复正常从而达到美容的目的。
美容是机体健康的外在表现,健康是一切美容的基础,健康源自细胞活力,细胞青春活力是细胞美容的基石。
(一)什么是细胞? 细胞是一切生命的最小基本组成单位,是能够独立生存的最小生命体.人体大约由60万亿个细胞所构成,人体皮肤最薄处也有十九个细胞构成其厚度。人体是由细胞构成的,细胞是人体的最基本单位,人的衰老就是细胞的衰老,细胞构成了人体的各种组织器官。人体就如一台机器,各组织器官就如机器的各个部件,损耗就相当于器官的衰老,所以人的肌肤就会出现问题,就是由于人的机体各个组织器官衰老或病变得表现。给衰老的细胞提供充足的营养,增强细胞的免疫能力,用自身的细胞修复病变的或受损的人体各个组织或器官,从而达到人体机能的年轻化、健康化,从而解决了各种肌肤表现出的问题,如、青春痘、*疮痤**、皱纹等,达到美容的效果;机体健康的标志是细胞,细胞构成了人体的各种组织器官。细胞具有再分裂产生新细胞的能力和新细胞具有生长发育的能力,细胞具备了旺盛的生长代谢功能,才能呈现出细胞青春活力。拥有了青春活力的细胞,机体才有健康保证,所以说细胞活力是机体健康的标志,也是一切美丽的基础。这种细胞正常更新的能力越强,就表示细胞越健康,细胞越健康,人体才能"自自然然健健康康"的美丽。(二)细胞美容学的要素 拥有细胞的青春活力,就拥有了健康,才能享受美容。美容是一切健康的表现,恢复机再生活力是一切健康的基石。细胞青春活力就是健康带来美容,等于就是。从细胞生物学角度来讲,要想留住青春,延缓衰老只有二种方法:
其一是使人体整个组织新细胞的能力与速度强于死亡的能力与速度,使组织活跃新生细胞增多,机体组织始终处于年轻态,甚至出现逆龄生长的现象。这就是人们常说的"你怎么越来越年轻,逆生长了吧?!"。
其二是持续的供给细胞足量的营养,维持及调动细胞的正常代谢功能,使细胞衰老周期延缓。"你还是像过去一样年轻"。前者是改善细胞自身功能,促进新生细胞增加,后者是改善环境,延长细胞生命周期。
"细胞美容学"的理论基础来自细胞学和生物胚胎学。理论依据是世界医学流行的""理论。"细胞美容学"的实践基础:"细胞排毒、细胞激活、细胞修复"是细胞美容学的三个要素。
细胞排毒是将细胞内部的经皮毒、重金属、氧自由基等毒素排出,使皮肤的肤质"土壤"发生改变。对于皮肤的、青春痘、斑点等问题,进行有效地解决。
细胞激活,通过激活细胞,激活休眠的表皮干细胞进行分裂,代替病变或衰老的细胞,同时营养成分供给细胞正常活动所需要的营养和能量,让年轻充满活力的细胞对问题皮肤进行修补,达到美容的效果。使组织活跃的新生细胞增多,机体组织始终处于年轻态,甚至出现逆龄生长的现象。
细胞修复,快速的修复受损或衰老细胞,对皮肤出现的皱纹、松弛、下垂见效快。对病变和衰老的组织和器官的细胞进行替代或复制,让机体内在年轻化、健康化,从而表现在外在的皮肤。二、影响细胞美容的因素
人体从生长、发育、衰老到死亡,影响肌肤细胞美容的因素是多方面的,但从细胞生物学角度观察可分为外界因素和内部因素。(一)外界因素 影响细胞美容的外界最直接的因素是大气环境,如大气污染造成的--、,大气中的酸碱含量,粉尘、沙粒。其次是辐射如紫外线。其三是表皮所接触到的固体、水质的影响。其四是表皮使用的即化妆品的潜在影响。外界因素对肌肤细胞美容影响最大的是辐射,它会造成细胞损伤,形成色素沉着、肌肤黯淡。其次是一些化学合成剂制造的化妆品对肌肤有沉积性累积伤害,使肌肤失去幼嫩光泽。即日用化妆品的使用对肌肤有的是弊大于利,而不是利大于弊。(二) 内部因素 我们把内部因素按照其影响的作用来区别又可分为不可改变因素和可改变因素。
1、不可改变的内部因素是指人体遗传因素对美容的影响,如长相,皮肤汗腺的分布。皮肤的属性分为,,或。皮肤毛孔的大小等都属于遗传因素造成的,这些性状是后天不可改变的。因此肌肤特性的不同,就决定了你选择美容方式和产品类型种类的不同,哪一种更适合你的肌肤。
2、影响细胞美容可改变的内部因素按功能作用可分为营养和细胞功能因素。
营养环境因素延缓衰老,留住美丽的方法:
改善肌肤细胞环境的,使细胞营养得到改善和补充,延缓细胞衰老周期。
细胞功能因素延缓衰老,留住美丽的最有效方法:
排出细胞毒素,激活细胞代谢的功能成份和活性,修复细胞再生能力,使细胞具有青春活力。细胞功能包括细胞生长,,,,DNA、RNA以及新细胞生成所需的各种合成。三、细胞美容与其他美容的区别(一)、生活美容 生活美容是泛指道具、装饰的美容,塑造一张娇艳动人的脸。它包括眉装、眼装、唇装、彩装,改装肤色;穿着打扮,美发等,就像一座建筑物的外观需要涂刷灿烂绚丽的油漆,给人以外在的美观。(二)、医学美容医学美容采用指两种方式到达美容的疗效:一是通过改善营养或肌体代谢达到增白、润肤等美容效果;二是采用或设备对现有容貌进行手术来达到美容的效果,如,作等。就像一座已建成的建筑物需要进行装修以消除缺陷达到美丽的感观。(三)、细胞美容 细胞美容是从人的出发,从特征及代谢功能入手,采用纯天然,通过高新生物技术手段,使人获得自然的健康,并表现出自然的美丽。因此谁拥有了细胞青春活力,谁就拥有了健康,谁才能享受到美容。就像一座美丽漂亮的建筑物,其本身的结构就拥有着结构的美。如果把美容当作一座建筑物,生活美容体现的就是装饰;医学美容就是装修;而细胞美容就是塑造美的结构。肌肤之美伴随着年龄的增长,时光在每一位爱美的女人脸上留下了特有的印记:皱纹、斑点、粗糙…女性所具有的青春和魅力也在逐渐锐减,原来水嫩白净、漂亮美丽的面容逐渐变的皱纹、灰暗,魅力尽失。女性皮肤是否细腻亮丽,肤色是否红润健康,衰老是否得以延缓。根本取决于皮肤细胞组织的健康与活力。不同年龄阶段,女性细胞组织健康与活力程度有所不同,相同年龄阶段女性由于细胞组织,健康与活力组织程度也有所不同,保持皮肤细胞组织的健康与活力,才能保证皮肤肌体的健康,才能更好的达到或实现肌肤细致亮丽,肤色红润健康,衰老得以延缓。这是女性共同追求的目的。
细胞之美

——细胞活力与细胞水化的意义 细胞自身含水、蓄水的能力被称之为"细胞水化"。 它是衡量皮肤含水量,反映皮肤以及皮肤细胞活力的重要因素.。细胞以及细胞组织间隙在自身状态下吸收蓄积水分的能力越强,即细胞、细胞组织间隙水化能力越强。细胞水化能力强时,肌肤就会光滑幼嫩,有光泽富有弹性,并能够有效抑制皱纹的形成与增长,同时淡化色斑,因此保持细胞的水化能力是肌肤健康靓丽的重要保证。细胞水化能力的强弱,取决于细胞内的某些物质,即细胞营养物。在青春期和幼儿期,细胞营养物质充足,细胞分裂增殖变快,即细胞水化能力就强,皮肤表现有弹性、细腻、无皱纹、无斑点。
细胞美容与传统化妆品的三大区别:1:传统美容品只能表皮吸收,而细胞美容采用纳米技术,能使及细胞食物渗透到和皮下组织,对皮肤深层细胞发挥作用。2:传统美容品只能进行普通的肌肤护理,而细胞美容能使干瘪枯萎的衰老细胞,重新变的充盈圆润,从根本上恢复细胞活力,让细胞变年轻。3:传统美容品只能对已生细胞进行维护,而细胞美容则能清除死去的衰老细胞,并且促进细胞再生,分裂,凋亡过程。
四、细胞美容学综述
人类从出生到成熟,从年轻到衰老是大自然特有的规律,谁也无法抗拒,但是凭借现代科学技术的进步,生物技术完全可以延缓细胞衰老,促进细胞的新生,从而延缓组织肌体的衰老,达到延缓容貌衰老的目的。 90%的人群肌肤组织处于亚健康状态,她们最直接的表现是肌肤细胞再生能力下降,功能代谢下降造成肤色萎黄暗淡无光泽,弹性差,色斑易沉积,皱纹增多,肌肤细胞功能下降,抵抗力减弱,肌肤细胞易疲劳、衰老形成大量皱纹。细胞美容能促进多种细胞分裂和新细胞再生,提高皮肤水化功能和间隙水化功能,全方位改善人体新陈代谢,从细胞水平进行调整。
细胞美容是人体皮肤美容护理的。通过细胞排毒、细胞激活、细胞修复来完成美白、抗衰的全方位解决攻略。属于美容行业微整形技术领域的一项重大突破。是当今美容行业的一次革命。
第二章:细胞美容疗法
一、美丽的转折Turning point
很多人认为"老化"是25岁以后开始的,但事实上人的肌肤从出生起,就开始历经成长及老化的过程,人体的衰老表现在皮肤上最为明显,当皮肤出现黑斑、暗沉、角质增浓.....即是衰老的开始!
人体是从卵子时期的一个基本细胞,受精后开始分裂增加一新陈代谢。当15岁左右时人体细胞总数即达到最尖峰,此后即开始减少。这是因为霉素的堆积,自由基的噬虐,慢慢的破坏了人体细胞的胚胎原质,阻碍了新陈代谢的活力,使得组织器官、腺体及免疫能力等功能减弱,导致老化及生病。
以上是25岁前的老化状况,这种外因性的老化还可以籍由耐心保养而得到大幅的改善,而25岁以后因遗传密码导致的内因性老化,才是速度加剧,不可逆的老化,最主要的原因是人体蓝图DNA所控制的2万5千个基因,让细胞分泌各种超过十万种的细胞生物素,在25岁以后种类不断变少,浓度也不断降低,使得己惯于拥有这些细胞生物素的身体,开始踏上老化的不归之路。。。。
细胞激活及修复与细胞数量和质量正相关。细胞主要是通过调节蛋白质、糖和脂肪等物质的代谢与水盐代谢,维持代谢的平衡,为生理活动提供能量;促进细胞的分裂与分化,确保各组织、器官的正常生长、发育及成熟,并影响衰老过程;影响神经系统的发育及其活动;促进生殖器官的发育与成熟,调节生殖过程;与神经系统密切配合,使机体能更好地适应环境变化。
现代生物科学研究发现,人在10—15岁时脏器发育最鼎盛,各种脏器再生的新生细胞数量也相对发展到高峰,25岁以后,人体的细胞活性开始大幅衰减,细胞也相应的衰老和功能减退甚至变异.
衰老除了和细胞数量、活性有关之外,还与激素水平有直接的关系:1hymus Extract(胸腺素)、Serum Extract(血清素)、Placenta Extract(胎盘素)、Embryo Extract(胚胎素)、Spleen Extract(脾脏素)、Salivary Extract(唾液腺素)六大类的分泌不足和体内浓度相对不足加速了人类的衰老和皮肤色斑、暗沉、粗糙......
人的衰老首先是细胞的衰老和功能减退。影响人衰老是人体内多脏器分泌减低或停止的综合表现

二、细胞美容的发展
瑞士Switzerland
瑞士这个西欧的中立小国家,不但得天独厚拥有了山明水秀的山光水色,各式民生科技也没有因战乱而被干扰,更发展出了超越各国之极高水平的生物科技,其中更包括了独步全球的"青春永驻"、"延年益寿"。的高科技生物技术产品,数十年来一直都为全世界的皇室贵族巨商富贾服务。
破解生命科学的秘密——细胞美容疗法
一个猜想:如果能从健康细胞取得活性成分,供给出现缺陷和失去活性的细胞,以使它们达到正常功能状态,细胞则实现一面修补一面更新成为健康的细胞。完整等同:中医理论的"吃肝补肝,吃脑补脑"。
以早在1912年,诺贝尔奖得主Alexis Carrel博士就提出鲜活年轻细胞能使老化细胞重新活化的理论。近60年来,瑞士利用现代高科生物技术萃取活性细胞生物素产物:如蛋白质、胜肽、脂肪和多醣体等,制成药品用于预防和治疗。
细胞生物素分子疗法是借助于高科技生物萃取技术,将动物腺体中与人类相似的、天然的调控和代谢物质分离出来,作为医学应用,透过生理机制将受损的调节修复,以协助和调整和维护体内生态平衡,恢复健康完美境界。

细胞美容疗法让女人的梦想即成现实!
瑞士活细胞美容疗法至今已有100年以上的研究历史,是抽取与人类有数万年亲缘关系的药用健康牛羊体中之特定组织、器官和腺体细胞以活细胞无性培养而成,所培养出的特殊组织细胞素(Extract of Specific Tissue Cells),如羊胎素胸腺素、血清素、胚胎素、脾脏素、唾液腺素等,以注射、舌下吸收、口服或皮肤吸收等各种方式使老化及受损的组织细胞增加分裂及活化,用以恢复身体机能,并加强免疫抗原的活力、动力。
每个女人梦想都成真
特殊组织细胞疗法

特殊组织细胞疗法(STCT: Specific Tissue Cells Therapy)是细胞美容疗法在美容抗衰老方面的顶级之作,她依个人肤质老化现象,量身定制出个人专属的抗老回春计划,帮助每个女人对抗自然老化,实现内外兼修,极致娇美,娇颜永驻的梦想。
Royal shared with the beautiful
与皇室贵族巨商富贾共享美丽

全世界的皇室贵族、巨商富贾、影星,数十年来每年都不断接受瑞士最极致的抗衰老服务。其中包括:教宗保禄十二世、日本裕人天皇、阿拉伯绍德国王、英国皇室、西班牙皇后、也门国王、法国总统戴高乐、德国总理、英国首相邱吉尔、服装界名人克里斯廷迪奥、英国小说家毛姆、电影明星卓别麟、卡菜德伦、葛丽泰嘉宝、伊莉萨臼泰勒、尤伯连纳及千千万万各国不愿具名的富商大贾等,都定期到瑞士接受青春疗程,让自己有生之年保持在青春健康美丽的状态。
三、细胞美容技术:

Cell Culture一细胞培养法
Biological beaucy of a new era
科技引领生物美容新时代
采用欧洲最新科技方法,由于细胞发酵培养法混合酵母(基因植入)发酵法得到的"类动物器脏胜肽"成份,该产品有超过三个以上的"防火墙"来阻挡各种可能的动物疾病源。而产品内容物正确来说是一类动物器脏胜肽(Animal Organ Like Peptide)属胜肽类。且内容物都小于6000道尔顿,完全避免了含有易造成过敏及致病源的大分子蛋白质、病毒、病菌等物质。
国际分工链接:因为细胞培养生物素相关产品之开发从动物培养、细胞工程、发酵制程、原料提取、精炼,到产品规划、灌装制程。。。等。不但科技专精较杂,且规模庞大,非一个国家、地区、工厂可以完全其工,而是采取国际分工方式完成。例如:前半段工程(动物培养)在全世界畜牧业发达且非动物疾病疫区之地区如澳洲、南美洲、细胞库在美国(现在日本、台湾已建立,但规模并不大)、细胞选取分离工程在瑞士,产品规划及设计在瑞士。
细胞培养法细胞生物素提取图解
胸腺素
Thymus Extract

胸腺是人体抵抗细菌、病毒繁殖与新陈代谢不平衡时的重要中枢免疫器官。胸腺素具有增强细胞免疫功能和调节免疫平衡等作用,胸腺素可使由骨髓产生的干细胞转变为T淋巴细胞,因而可增强细胞免疫功能。其特定组织细胞中所含[各种胸腺细胞因子]的滤液中,包含了许多可以诱导免疫功能的因子,这些因子对所有族群的身体免疫功能均能发挥作用,包括自然退化的或免疫功能疾病的。因此可以达到延长细胞寿命及刺激细胞分化的作用。
胸腺素的效用:
<1>诱导和促进T-细胞分化、成熟;
<2>增加巨噬细胞吞噬功能;
<3>提高自然杀手细胞的活力;
<4>增加干扰素的产生;
<5>增强血清中SOD的活性;
<6>提高免疫力等。
血清素Serum Extract
血清因子可改善细胞对氧及能量利用的作用,对循环不良引起的机体环境异常,有显著的正向效应,因子可提高摄氧能力,促进细胞对葡萄糖的摄取和利用(不依赖胰岛素)增加细胞对氧的吸收和利用,促进ATP生成增加,使细胞携氧能量提高,改善细胞功能,增强血管通透性,从而使血流增加及细胞活性及修护力提升。
血清素的效用:
<1>适用于脑血管疾病、痴呆、颅内出血硬外伤。
<2>糖尿病多发性神经病变。
<3>周边血管血流阻碍引起的疾病{糖尿病性坏疽、足溃疡) 。
<4>烧伤、烫伤、皮肤溃疡、促进伤口愈台、改善整容后的伤口。
<5>胃溃疡。
<6>刺激胶原的合成。
脾脏素
Spleen Extract
脾脏和胸脏一样,属于淋巴系统一部份,脾脏素对皮肤组织再生、(新陈)代谢刺激及人体皮肤的组织结构,有活化和再活化的功效。脾脏素能够加速组织废物的衰退和排除,以及因合成新物质所引起的组织调节。这样的刺激因皮肤的调节作用活络,而有助于改善皮肤功
能,达到延迟肌肤老化的目的。
脾脏素的效用:
<1>促进及控制造血;
<2>吞噬作用;
<3>储存功能(血液、血小板、factorⅦ、铁);
<4>免疫功能(制造抗体);
<s>改善男性性功能。
<6>改善女性更年期:潮红、沮丧、注意力及睡眠受损、其它更年期等症状
<7>改善代谢失调:生长腺体所引起,例如动脉硬化、骨质疏松等症;
<8>改善心跳加速、疲倦、注意力失调、紧张、暴躁。
<9>延缓衰老。
胎盘素
Placenta Extract

胎盘素及其成份的重要作用为提供器官在发展时的必要养份和物质,在胎盘中已发现超过100种以上的成份,包含磷水化合物、脂肪、脂类、氯基酸、胜肽、蛋白质、矿物质,及其它具生理调节的成份如酵素、维他命、荷尔蒙、凝血因子、红血球生长素、多醣体等重要成份。在"胎盘特定组织细胞"中所含细胞因子的滤液中,包含了许多可以诱导细胞及组织器官功能之因子.这些因子对所有族群的细胞及身体系统功能均能发挥作用,包括那些自然退化期的身体功能。因此可以达到延长细胞寿命,增进器官功能的延缓老化作用。
胎盘素的效用:
<1>促进血液循环:
<2>促进细胞生长:
<3>促进白血球吞噬病原菌的作用:
<4>强壮作用:
疲劳、初期性的老化:
年老现象的显示、因年老所引发的疾病;
增强抗体对有害因素的抵抗力。
在美容医学的临床上,胎盘素中的红血球生长素有促进肌肤细胞新生的功效。因此常用于配台果酸换肤、雷射、磨皮或是使用维他命A酸等,来加速皮肤的恢复,井降低此时肌肤的敏感性及发炎后色素沉着的可能。
胚胎素
Embryo Extract

早在1912年,诺贝尔奖得主A,Carre博士的研究,就已证实年轻细胞素对老细胞催化作用的存在。以干细胞培养后所含胚胎原质的滤液中,包含了许多可以诱导生长发育的因子,这些因子对所有族群的细胞均能发挥作用,包括了那些将达到自然风化期的细胞。因此可以达到延长细胞寿命及刺激细胞分化的作用。这也就是说明了胚胎素的效能,主要是来自于年轻细胞的催化功能,重建人体组织的生化秩序,以干细胞活化因子成分对其特定的组织系统发生功效。
胚胎素的效用:
<1)增进蛋白质的生物合成,病后或手术后身体机能之恢复;
<2>刺激及增强老化细胞的代谢与活化.延缓老化过程,明显回春作用:
<3>改善肌肤的活力与弹性,作用于细胞的新陈代谢。能使皮肤基底层的黑色素及毒素快速排出,达到美白淡斑,加强皮肤组织保温及吸收营养等能力:
<4>增进患者免疫系统及改善整体的健康情况;
<5>工作过度疲劳,压力过大造成精神沮丧,改善生理及心理的状态:
<6>自觉精神与体力处于低峰期,可有效的体能提升、精神舒爽。
唾液腺素
Salivary Extract
唾液腺是高等动物为了消化、防卫(免疫)及保持口腔清洁为目的的特殊腺体,在细胞生物学家不断的研究累积后,发现唾液腺体功能远远较我们粗浅的认识还要多的多,从其腺体提取物(SGE)的各种细胞生物素中,科学家不断的有惊喜的发现,唾液腺素(多胜混台物),不但具有提升免疫、促进细胞活化、生长、伤口愈合等功能外,还可以协同促进身体其他器官发挥箕更完整的功能。像是对身体免疫系统的胸腺组织具协同作用、提高体内细胞扩清自由基功能、降低血清中胆固醇功能、迅速代谢血清醣份及促进延缓老化等功能。
唾液腺素的效用:
<1>促进成纤维细胞生长、帮助伤口愈合
<2>提升体循环系统中红细胞SOD活性
<3>降低血清LPO含量(降低血清中低密度胆固醇)
<4>协同胸腺免疫功能,提高胸腺指数
<5>促进细胞生长,其明显抗衰老作用
四、干细胞美容疗法
一种用人体自身皮肤干细胞来进行除皱除美容的技术,用自己的为自己美容,被称为"一场除皱美容的生物革命"。但目前这一技术还在实验室阶段。干细胞移植技术能达到除皱、、祛疤等效果。
干细胞(stem cells, SC)是一类具有自我复制能力(self-renewing)的,在一定条件下,它可以分化成多种功能细胞。根据干细胞所处的分为胚胎干细胞(embryonic stem cell,)和成体干细胞(somatic stem cell)。根据干细胞的分化潜能分为三类:(totipotent stem cell,TSC)、(pluripotent stem cell)和(unipotent stem cell)。干细胞(Stem Cell)是一种未充分分化,尚不成熟的细胞,具有再生各种组织器官和人体的潜在功能,医学界称为"万用细胞"干细胞"一词最早出现于19世纪的生物学文献中,而干细胞的研究被认为开始于1960年代,随着干细胞的功能不断的被发现,干细胞的研究在自然科学领域中也越来越引人注目,其神秘的面纱也随着不同时代的科学家们不断的探索和研究而逐渐揭开。
美国科学家在干细胞相关研究这么多年的发展中,干细胞美容的真正应用还只在整形外科,干细胞美容的相关研究更多是在实验室的研究阶段,干细胞产品真正推向了市场指日可待。
干细胞美容不再从外源性的干细胞着手,而是致力于促进自身皮肤干细胞的生长和恢复,通过外界给予特定的部位涂抹一些具有活性AFA干细胞激活剂的小分子物质,可以达到刺激"唤性"或营养表皮或真皮干细胞。表皮干细胞被小分子的生物活性肽所唤醒的作用是:
1、在表皮水平上:影响角化细胞的活性和生长因素,刺激角化细胞迁移和上皮化,刺激表皮细胞分化和矫正,强烈促进表皮修复和愈合。
2、在真皮水平上:刺激成纤维细胞活性,增强细胞外基质收缩和构造,提供皮肤养分促进皮肤伤口愈合和功能再生。
3、在皮肤整体水平上:增强对环境侵袭、紫外线、污染物、刺激物、敏化剂、炎性细胞的抵抗力,巩固、增强皮肤张肌,增强皮肤弹性,刺激疤痕组织褪色,减少瘢痕形成,延缓皮肤衰老。
其主要机制有:①促进表皮和真皮层细胞(特别是成纤维细胞、上皮细胞、内皮细胞)增殖、分裂、分化,新生细胞增多,使皮肤增厚,逐渐恢复皮肤正常结构和生理功能;②促进胶原纤维、网状纤维、弹性纤维的形成,调节胶原蛋白和粘多糖的分泌,维持皮肤组织中水分含量和电解质代谢,改善萎缩皮肤的缺水状态,滋润皮肤组织;③通过对血管内皮细胞的作用,促进皮肤组织不断形成新的毛细血管。
采用纯物理提取方法从生长于美国俄勒岗州,克拉玛斯湖(天然火山湖泊-丰富的火山矿物),丝状淡水蓝绿藻植物,纯浓缩萃取束丝藻 (AFA)。其对人表皮干细胞的作用机理和动物模型的实验研究发现,具有多种重要的生物学效应和生理功能。在体外培养人体的上皮细胞、成纤维细胞、血管内皮细胞及角膜细胞的培养基中加入鱼子多肽原液,可显著加速这些细胞的分裂和增殖;在近七年多的实践和近万人次的应用中,发现鱼子多肽原液有非常明显的改善不健康的皮肤状态,如皮肤皱纹、松弛、色斑、暗逗、肤色灰暗等,并且是极其安全的。这进一步说明AFA与皮肤细胞的生长、分裂、分化、增殖和迁移有关,它们能够提供皮肤养分,延缓皮肤衰老,促进皮肤创面修复。
实验研究和临床应用均表明,将AFA加到美容化妆品中,可以有效地与皮肤细胞发生作用,发挥其突出的美容护肤功效,对于护肤品功能提高具有重要意义。
当干细胞源源不断地满足皮肤需要时,皮肤的健康就会得到保证,各种皮肤问题就可以被有效地预防,皮肤就可以重新回到更年轻更健康的状态,做到真正由内而外的美丽。
干细胞在生命科学的基础研究与临床应用中起着越来越重要的作用,干细胞在细胞治疗、组织器官修复、发育生物学、药物学等领域有着极为广阔的应用前景。干细胞能够作为细胞治疗与组织器官替代治疗的种子细胞、探讨胚胎发育的调控机制、作为疾病基因治疗的载体、体外整合外源基因以研究基因功能、用于建立药物筛选平台而致力于药理研究与新药开发等等。采用干细胞治疗有着多种优势:低毒性(或无毒性),即使不完全了解疾病发病的确切机理治疗也可达到较好的治疗效果,自身干细胞移植可避免产生免疫排斥反应,对传统治疗方法疗效较差的疾病多有惊人的效果。当前,干细胞和再生医学的研究已成为自然科学中最为引人注目的领域,其理论的日臻完善和技术的迅猛发展必将在疾病治疗和生物医药等领域产生划时代的成果,是对传统医疗手段和医疗观念的一场重大革命。